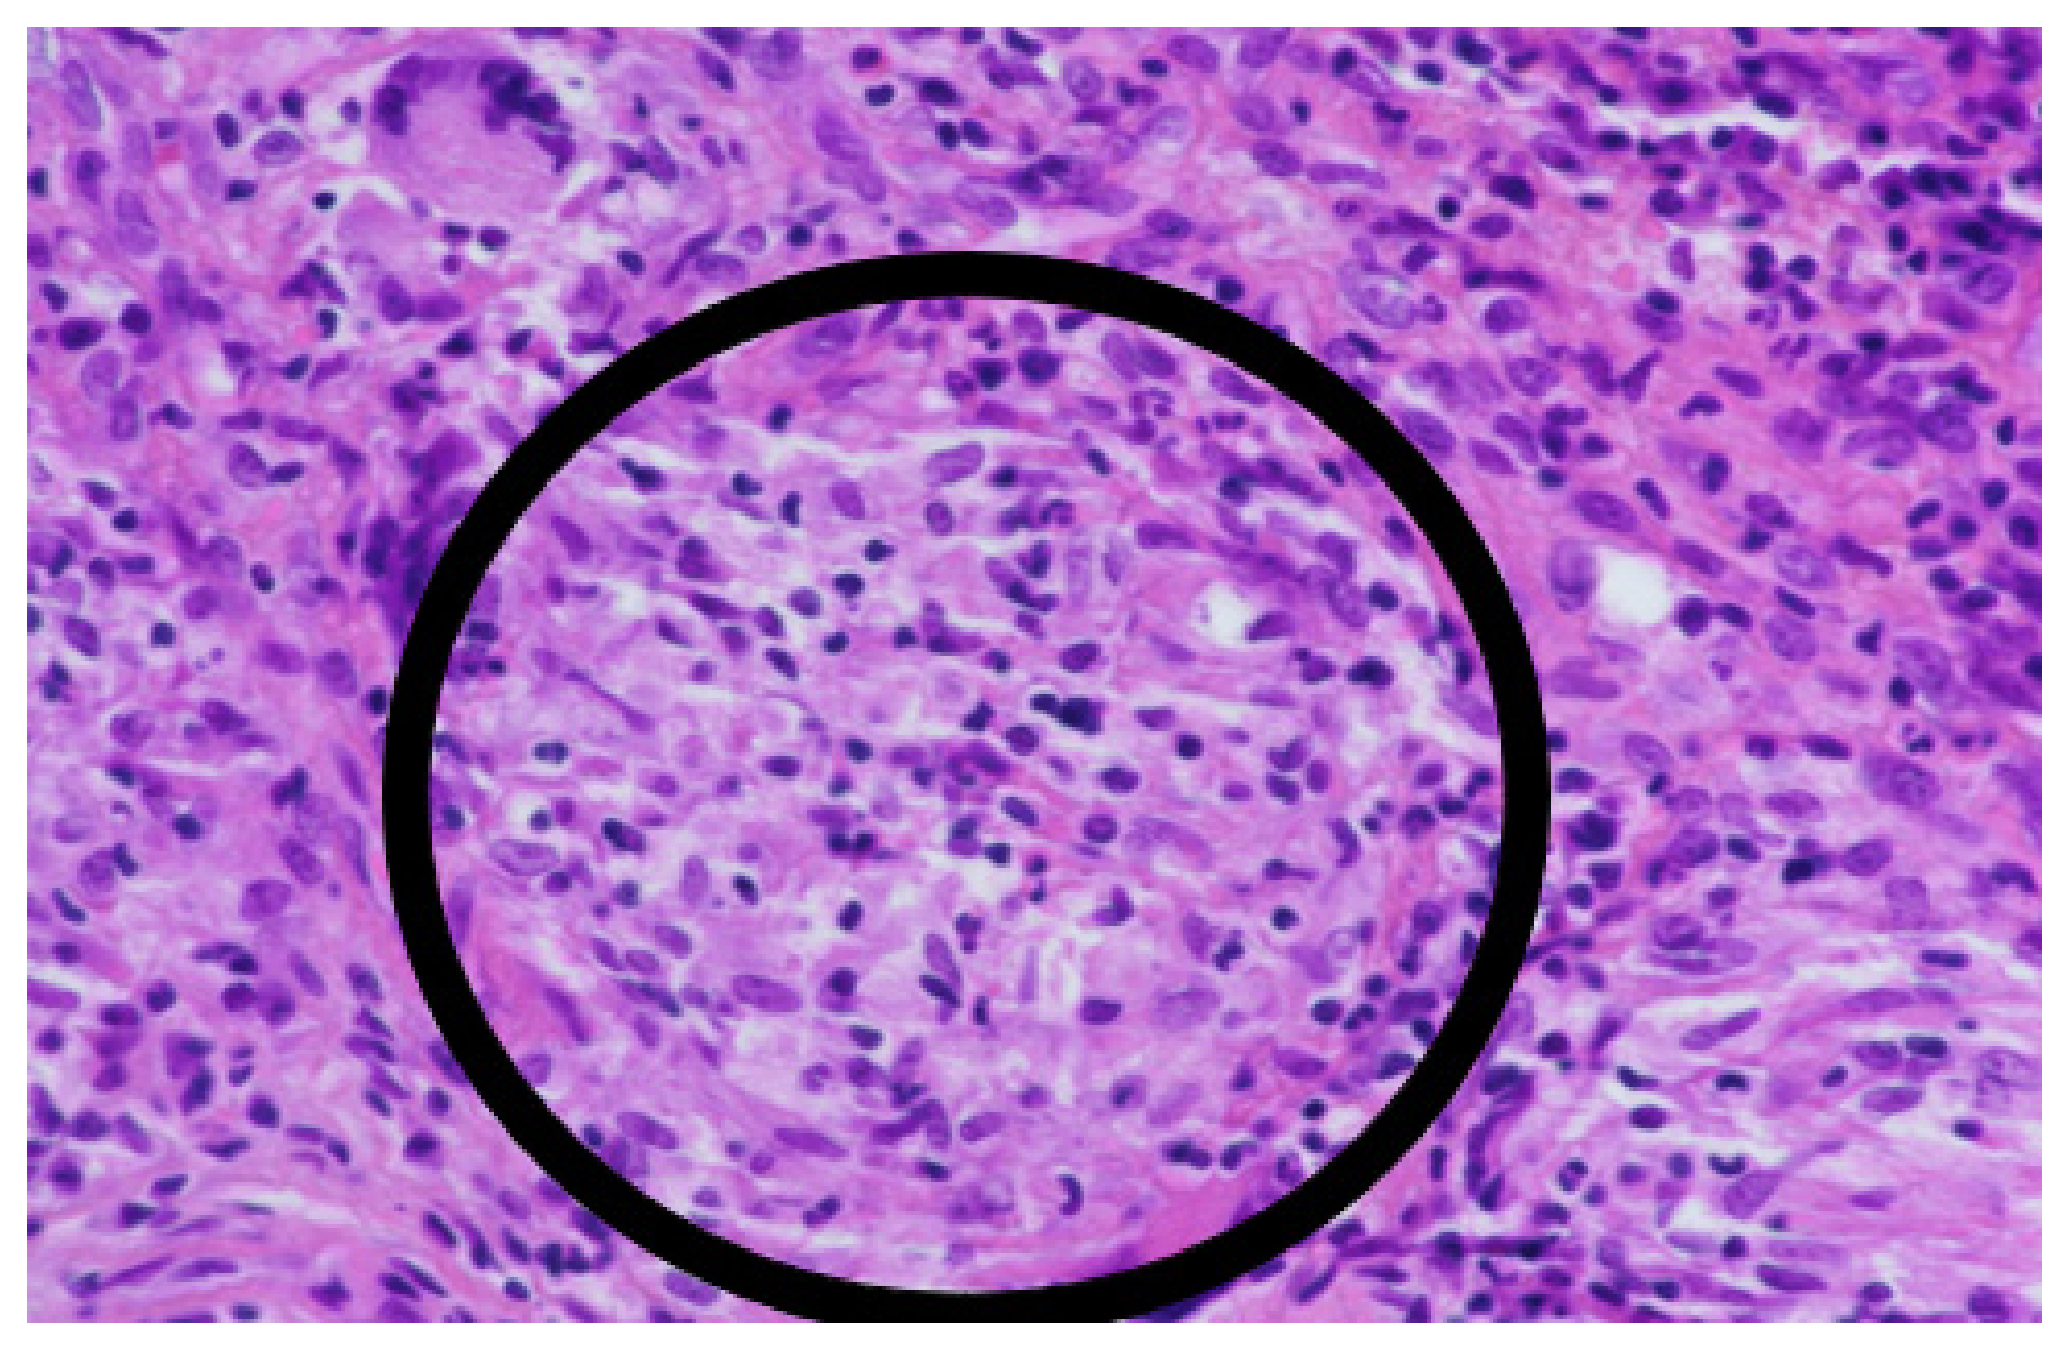
Antibiotics 12 00097 g003 Antibiotics 12 00097 g003

A Rare Case of Osteomyelitis of an Ankle Caused by Mycobacterium chelonae
Abstract
1. Case Report
2. Literature Review and Discussion
3. Materials and Methods
4. Conclusions
Supplementary Materials
Author Contributions
Funding
Institutional Review Board Statement
Informed Consent Statement
Data Availability Statement
Conflicts of Interest
References
- Clinical and Laboratory Standards Institute. Susceptibility testing of mycobacteria, Nocardia spp, and other aerobic actinomyces. In CLSI Standard M24, 3rd ed.; Clinical and Laboratory Standards Institute: Wayne, PA, USA, 2018. [Google Scholar]
- Waldvogel, F.A.; Medoff, G.; Swartz, M.N. Osteomyelitis: A review of clinical features, therapeutic considerations and unusual aspects. N. Engl. J. Med. 1970, 282, 198–206. [Google Scholar] [CrossRef]
- Griffith, D.E.; Aksamit, T.; Brown-Elliott, B.A.; Catanzaro, A.; Daley, C.; Gordin, F.; Holland, S.M.; Horsburgh, R.; Huitt, G.; Iademarco, M.F.; et al. An official ATS/IDSA statement: Diagnosis, treatment, and prevention of nontuberculous mycobacterial diseases. Am. J. Respir. Crit. Care Med. 2007, 175, 367–416. [Google Scholar] [CrossRef]
- Lee, M.R.; Sheng, W.H.; Hung, C.C.; Yu, C.J.; Lee, L.N.; Hsueh, P.R. Mycobacterium abscessus Complex Infections in Humans. Emerg. Infect. Dis. 2015, 21, 1638–1646. [Google Scholar] [CrossRef]
- Kemp, D.M.; Govind, A.G.; Kang, J.; Brugger, C.C.; Kauh, Y.C. Sporotrichoid-Like Spread of Cutaneous Mycobacterium chelonae in an Immunocompromised Patient. Case Rep. Dermatol. Med. 2017, 2017, 8219841. [Google Scholar] [CrossRef]
- Lee, W.J.; Kang, S.M.; Sung, H.; Won, C.H.; Chang, S.E.; Lee, M.W.; Kim, M.N.; Choi, J.H.; Moon, K.C. Non-tuberculous mycobacterial infections of the skin: A retrospective study of 29 cases. J. Dermatol. 2010, 37, 965–972. [Google Scholar] [CrossRef]
- Talanow, R.; Vieweg, H.; Andresen, R. Atypical Osteomyelitis Caused by Mycobacterium chelonae-A Multimodal Imaging Approach. Case Rep. Infect. Dis. 2013, 2013, 528795. [Google Scholar] [CrossRef]
- Tanagho, A.; Hatab, S.; Hawkins, A. Atypical Osteomyelitis Caused by Mycobacterium chelonae in a Nonimmunocompromised Patient: A Case Report. JBJS Case Connect. 2015, 5, e17. [Google Scholar] [CrossRef]
- Brown-Elliott, B.A.; Philley, J.V. Rapidly Growing Mycobacteria. Microbiol. Spectr. 2017, 5, 703–723. [Google Scholar] [CrossRef]
- Kumar, C.; Shrivastava, K.; Singh, A.; Chauhan, V.; Varma-Basil, M. Skin and soft-tissue infections due to rapidly growing mycobacteria: An overview. Int. J. Mycobacteriol. 2021, 10, 293–300. [Google Scholar] [CrossRef]
- Marino, A.; Caltabiano, E.; Zagami, A.; Onorante, A.; Zappala, C.; Locatelli, M.E.; Pampaloni, A.; Scuderi, D.; Bruno, R.; Cacopardo, B. Rapid emergence of cryptococcal fungemia, Mycobacterium chelonae vertebral osteomyelitis and gastro intestinal stromal tumor in a young HIV late presenter: A case report. BMC Infect. Dis. 2018, 18, 693. [Google Scholar] [CrossRef]
- Bi, S.; Hu, F.-S.; Yu, H.-Y.; Xu, K.-J.; Zheng, B.-W.; Ji, Z.-K.; Li, J.-J.; Deng, M.; Hu, H.-Y.; Sheng, J.-F. Nontuberculous mycobacterial osteomyelitis. Infect. Dis. 2015, 47, 673–685. [Google Scholar] [CrossRef]
- Gaudencio, M.; Carvalho, A.; Bertao, M.I.; Barreiro, I.; Bessa, M.I.; Goncalves, A. Mycobacterium chelonae Cutaneous Infection: A Challenge for an Internist. Eur. J. Case Rep. Intern. Med. 2021, 8, 003013. [Google Scholar] [CrossRef] [PubMed]
- Goldstein, N.; St Clair, J.B.; Kasperbauer, S.H.; Daley, C.L.; Lindeque, B. Nontuberculous Mycobacterial Musculoskeletal Infection Cases from a Tertiary Referral Center, Colorado, USA. Emerg. Infect. Dis. 2019, 25, 1075–1083. [Google Scholar] [CrossRef] [PubMed]
- Churgin, D.S.; Tran, K.D.; Gregori, N.Z.; Young, R.C.; Alabiad, C.; Flynn, H.W., Jr. Multi-drug resistant Mycobacterium chelonae scleral buckle infection. Am. J. Ophthalmol. Case Rep. 2018, 10, 276–278. [Google Scholar] [CrossRef]
- Lowell, D.L.; Jean-Claude, J.M.; Fuchs, L. Infectious Tenosynovitis of the Tibialis Anterior Due to Mycobacterium chelonae After Intravenous Heroin Injection. J. Foot Ankle Surg. 2020, 59, 413–417. [Google Scholar] [CrossRef]
- Pavlik, I.; Ulmann, V.; Hubelova, D.; Weston, R.T. Nontuberculous Mycobacteria as Sapronoses: A Review. Microorganisms 2022, 10, 1345. [Google Scholar] [CrossRef] [PubMed] [PubMed Central]
- Shih, D.C.; Cassidy, P.M.; Perkins, K.M.; Crist, M.B.; Cieslak, P.R.; Leman, R.L. Extrapulmonary Nontuberculous Mycobacterial Disease Surveillance—Oregon, 2014–2016. MMWR. Morb. Mortal. Wkly. Rep. 2018, 67, 854–857. [Google Scholar] [CrossRef]
- De Groote, M.A.; Pace, N.R.; Fulton, K.; Falkinham, J.O., 3rd. Relationships between Mycobacterium isolates from patients with pulmonary mycobacterial infection and potting soils. Appl. Environ. Microbiol. 2006, 72, 7602–7606. [Google Scholar] [CrossRef]
- Harp, G.M.; Achcar, R.D.; Drummond, W.K. Necrotizing osteomyelitis in a man with disseminated Mycobacterium chelonae infection. Idcases 2018, 12, 71–73. [Google Scholar] [CrossRef]
- Ueda, Y.; Tokumasu, K.; Hagiya, H.; Iio, K.; Fujimori, T.; Kakehi, A.; Okura, M.; Minabe, H.; Otsuka, F. Mycobacterium chelonae bloodstream infection induced by osteomyelitis of toe: A case report. J. Infect. Chemother. 2020, 26, 843–846. [Google Scholar] [CrossRef]
- Napaumpaiporn, C.; Katchamart, W. Clinical manifestations and outcomes of musculoskeletal nontuberculous mycobacterial infections. Rheumatol. Int. 2019, 39, 1783–1787. [Google Scholar] [CrossRef] [PubMed]
- Park, J.W.; Kim, Y.S.; Yoon, J.O.; Kim, J.S.; Chang, J.S.; Kim, J.M.; Chun, J.M.; Jeon, I.H. Non-tuberculous mycobacterial infection of the musculoskeletal system: Pattern of infection and efficacy of combined surgical/antimicrobial treatment. Bone Jt. J. 2014, 96-B, 1561–1565. [Google Scholar] [CrossRef]
- Fraga, K.; Maireles, M.; Jordan, M.; Soldevila, L.; Murillo, O. Mycobacterium fortuitum osteomyelitis of the cuboid bone treated with CERAMENT G and V: A case report. J. Bone Jt. Infect. 2022, 7, 163–167. [Google Scholar] [CrossRef] [PubMed]
- Omori, K.; Kitagawa, H.; Tadera, K.; Naka, Y.; Sakamoto, S.; Kamei, N.; Nomura, T.; Shigemoto, N.; Hattori, N.; Ohge, H. Vertebral osteomyelitis caused by Mycobacteroides abscessus subsp. abscessus resulting in spinal cord injury due to vertebral body fractures. J. Infect. Chemother. 2022, 28, 290–294. [Google Scholar] [CrossRef] [PubMed]
- Thwaites, V.; Colston, J.; Lomas-Cabeza, J.; Orosz, Z. Mycobacterium chelonae osteomyelitis presenting as a mycobacterial spindle cell pseudotumor. Int. J. Mycobacteriol. 2018, 7, 104–106. [Google Scholar] [CrossRef] [PubMed]
- Kim, C.J.; Kim, U.J.; Kim, H.B.; Park, S.W.; Oh, M.D.; Park, K.H.; Kim, N.J. Vertebral osteomyelitis caused by non-tuberculous mycobacteria: Predisposing conditions and clinical characteristics of six cases and a review of 63 cases in the literature. Infect. Dis. 2016, 48, 509–516. [Google Scholar] [CrossRef]
- Ulmann, V.; Modra, H.; Babak, V.; Weston, R.T.; Pavlik, I. Recovery of Mycobacteria from Heavily Contaminated Environmental Matrices. Microorganisms 2021, 9, 2178. [Google Scholar] [CrossRef]
- Zuluaga, A.F.; Galvis, W.; Jaimes, F.; Vesga, O. Lack of microbiological concordance between bone and non-bone specimens in chronic osteomyelitis: An observational study. BMC Infect. Dis. 2002, 2, 8. [Google Scholar] [CrossRef]
- Drancourt, M.; Raoult, D. Cost-effectiveness of blood agar for isolation of mycobacteria. PLoS Negl. Trop. Dis. 2007, 1, e83. [Google Scholar] [CrossRef]
- Adekambi, T.; Berger, P.; Raoult, D.; Drancourt, M. rpoB gene sequence-based characterization of emerging non-tuberculous mycobacteria with descriptions of Mycobacterium bolletii sp. nov., Mycobacterium phocaicum sp. nov. and Mycobacterium aubagnense sp. nov. Int. J. Syst. Evol. Microbiol. 2006, 56, 133–143. [Google Scholar] [CrossRef]
- Higgins, J.; Camp, P.; Farrell, D.; Bravo, D.; Pate, M.; Robbe-Austerman, S. Identification of Mycobacterium spp. of veterinary importance using rpoB gene sequencing. BMC Vet. Res. 2011, 7, 77. [Google Scholar] [CrossRef]
- Wi, Y.M. Treatment of Extrapulmonary Nontuberculous Mycobacterial Diseases. Infect. Chemother. 2019, 51, 245–255. [Google Scholar] [CrossRef] [PubMed]
- Koh, W.J.; Jeon, K.; Lee, N.Y.; Kim, B.J.; Kook, Y.H.; Lee, S.H.; Park, Y.K.; Kim, C.K.; Shin, S.J.; Huitt, G.A.; et al. Clinical significance of differentiation of Mycobacterium massiliense from Mycobacterium abscessus. Am. J. Respir. Crit. Care Med. 2011, 183, 405–410. [Google Scholar] [CrossRef] [PubMed]
- Hogan, J.I.; Hurtado, R.M.; Nelson, S.B. Mycobacterial Musculoskeletal Infections. Thorac. Surg. Clin. 2019, 29, 85–94. [Google Scholar] [CrossRef]
- Chakravorty, S.; Helb, D.; Burday, M.; Connell, N.; Alland, D. A detailed analysis of 16S ribosomal RNA gene segments for the diagnosis of pathogenic bacteria. J. Microbiol. Methods 2007, 69, 330–339. [Google Scholar] [CrossRef] [PubMed]
- Adekambi, T.; Colson, P.; Drancourt, M. rpoB-based identification of nonpigmented and late-pigmenting rapidly growing mycobacteria. J. Clin. Microbiol. 2003, 41, 5699–5708. [Google Scholar] [CrossRef] [PubMed]

Disclaimer/Publisher’s Note: The statements, opinions and data contained in all publications are solely those of the individual author(s) and contributor(s) and not of MDPI and/or the editor(s). MDPI and/or the editor(s) disclaim responsibility for any injury to people or property resulting from any ideas, methods, instructions or products referred to in the content. |
© 2023 by the authors. Licensee MDPI, Basel, Switzerland. This article is an open access article distributed under the terms and conditions of the Creative Commons Attribution (CC BY) license (https://creativecommons.org/licenses/by/4.0/).
Share and Cite
Ryskova, L.; Kukla, R.; Bolehovska, R.; Prokes, L.; Vajda, M.; Kucera, T.; Pavlik, I.; Bostik, P.; Ryska, P. A Rare Case of Osteomyelitis of an Ankle Caused by Mycobacterium chelonae. Antibiotics 2023, 12, 97. https://doi.org/10.3390/antibiotics12010097
Ryskova L, Kukla R, Bolehovska R, Prokes L, Vajda M, Kucera T, Pavlik I, Bostik P, Ryska P. A Rare Case of Osteomyelitis of an Ankle Caused by Mycobacterium chelonae. Antibiotics. 2023; 12(1):97. https://doi.org/10.3390/antibiotics12010097
Chicago/Turabian StyleRyskova, Lenka, Rudolf Kukla, Radka Bolehovska, Libor Prokes, Milan Vajda, Tomas Kucera, Ivo Pavlik, Pavel Bostik, and Pavel Ryska. 2023. "A Rare Case of Osteomyelitis of an Ankle Caused by Mycobacterium chelonae" Antibiotics 12, no. 1: 97. https://doi.org/10.3390/antibiotics12010097
APA StyleRyskova, L., Kukla, R., Bolehovska, R., Prokes, L., Vajda, M., Kucera, T., Pavlik, I., Bostik, P., & Ryska, P. (2023). A Rare Case of Osteomyelitis of an Ankle Caused by Mycobacterium chelonae. Antibiotics, 12(1), 97. https://doi.org/10.3390/antibiotics12010097

